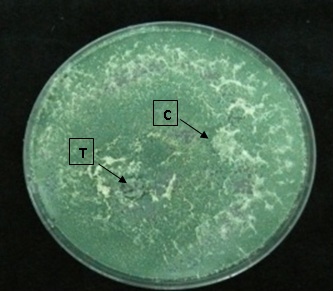
Dual culture of Trichoderma asperellum  Dual culture of Trichoderma asperellum

Aguín O.[1]1, Dalama J.1, Sainz M.J.2, Salinero M.C.1, Mansilla J.P.1
1Estación Fitopatolóxica do Areeiro, Subida a la Robleda s/n, 36153 Pontevedra, Spain
2Departamento de Producción Vegetal, Universidad de Santiago de Compostela, Campus Universitario s/n, 27002 Lugo, Spain
[1] Author for correspondent
Ciborinia camelliae Khon is a highly specialized pathogen that attacks the flowers of many species of Camellia, causing the disease known as camellia flower blight. It is considered the main phytosanitary problem for cultivars of Camellia spp. with ornamental value, since it causes the premature fall of the flower. The vast majority of cultivars are considered susceptible to the disease, although in the last decade some cultivars were found resistant (Taylor, 2004).
The European and Mediterranean Plant Protection Organization (EPPO) includes Ciborinia camelliae in the A2 list as quarantine organism (EPPO, 2011). At the moment, there is no fully effective treatment to cure camellias of the disease. The existing preventive strategies of disease control are based on the interruption of Ciborinia camelliae life cycle. The most effective preventive method is the removal of the flowers fallen on the ground in order to reduce the formation of sclerotia, which are resistant structures of the pathogen. Practices to create in the soil unfavorable conditions for formation and development of sclerotia, like pruning the lower plant branches and removing weeds to ensure good ventilation in the base of the plants, have also shown some proven efficacy.
Another strategy to control C. camelliae was focused on the application of chemical pesticides on flowers (van Toor et al., 2001), sclerotia (van Toor et al., 2002), or apothecia (van Toor et al., 2004), reducing some of them the viability of the fungus but only in vitro. In the field, only soil application of calcium cyanamide and bicarbonate salts has proven to be effective in preventing the development of apothecia in soil (van Toor et al., 2004). Unfortunately, neither calcium cyanamide nor bicarbonate salts affect the formation and viability of sclerotia in the petals.
In recent years the use of microbial antagonists for control of plant fungal diseases has received much attention. Fungi of the genus Trichoderma have been shown to be effective as biocontrol agents of several soil borne phytopathogens (Benítez et al., 2004), and could be useful agents to control fungal diseases affecting aerial parts of plants. In this work, we evaluated the in vitro antagonistic activity of two species of Trichoderma (T. harzianum and T. asperellum), obtained in two camellia nurseries in Japan (Genkai and Hisatoni), against Ciborinia camelliae.
Two isolates of Trichoderma asperellum and one of Trichoderma harzianum were obtained from the greenhouse soil of two camellia nurseries in Japan (Genkai and Hisatoni) (table 1), and were grown in Potato Dextrose Agar (PDA) medium at 25 ºC in the dark for about seven days. Trichoderma species were identified on the basis of their morphological characteristics and molecular techniques.
Table 1. Isolates of Trichoderma spp. obtained from greenhouse soil in two camellia nurseries in Japan.
| Isolate code | Trichoderma species | Source | Year of isolation | Location |
| G1 R3 | T. asperellum | Soil | 2010 | Genkai (Japan) |
| HR 4T | T. asperellum | Soil | 2010 | Hisatoni (Japan) |
| HR 7T | T. harzianum | Soil | 2010 | Hisatoni (Japan) |
Three isolates of Ciborinia camelliae were obtained from flowers of Camellia japonica plants growing in Pontevedra (NW Spain) (table 2), and cultured in PDA amended with streptomycin (PDAs) at 20 ºC in darkness. Fungal identification was done by observing morphological characteristics and by molecular methods.
Table 2. Isolates of Ciborinia camelliae obtained from flowers of Camellia japonica plants growing in Pontevedra (NW Spain).
|
Isolate code of Ciborinia camelliae |
Host |
Source |
Year of isolation |
Location |
|
EFA 866.2 |
Camellia japonica |
Camellia flower |
2010 |
Pontevedra (NW Spain) |
|
EFA 866.5 |
Camellia japonica |
Camellia flower |
2010 |
Pontevedra (NW Spain) |
|
EFA 909.1 |
Camellia japonica |
Camellia flower |
2010 |
Pontevedra (NW Spain) |
The competition between Ciborinia camelliae and the three antagonists (T. asperellum Genkai, T. asperellum Hisatoni and T. harzianum Hisatoni) were evaluated in dual cultures. For each Trichoderma and C. camelliae isolates combination, mycelia discs (5 mm diam.) of the potential antagonist and the pathogen were placed simultaneously 3 cm apart on a Petri dish. There were six replicates per combination and the corresponding controls (dishes with the plant pathogen or the antagonist alone). The plates were then incubated at 20 ºC under a L:D 12:12 h photoperiod for 6 days. Colony growth of the pathogen and the antagonists was recorded after 4 and 6 days. Growth of C. camelliae cultivated alone was used to estimate the percent growth inhibition of the pathogen by the antagonists.
After 4 days of culture, no growth of C. camelliae isolates was observed, while the three isolates of Trichoderma formed colonies of 2.1-2.5 cm in diameter, either in dual cultures or the corresponding controls.Under the experimental conditions, Trichoderma isolates grew faster than those of C. camelliae. Only after 6 days of growth, the control colonies of both T. asperellum and T. harzianum isolates occupied the entire Petri dish. At that time, isolates of C. camelliae had grown 4-4.5 cm in diameter (Table 3).
Table 3. Colony diameter of three isolates of Trichoderma spp. and three isolates of C. camelliae in control cultures after 4 and 6 days of growth at 20 ºC.
| Colony diameter (cm) | ||
| 4 days of growth | 6 days of growth | |
| T. asperellum Genkai | 2.2 | 8.6 |
| T. asperellum Hisatoni | 2.3 | 8.6 |
| T. harzianum Hisatoni | 2.1 | 8.6 |
| C. camelliae EFA 866.2 | 0 | 4 |
| C. camelliae EFA 866.5 | 0 | 4.5 |
| C. camelliae EFA 909.1 | 0 | 3.9 |
When grown in dual culture, overgrowth and sporulation of Trichoderma isolates on all C. camelliae isolates were observed (Figure 1). A reduction of the colony diameter of C. camelliae was also noted (Table 4), thus indicating an antagonistic effect of Trichoderma isolates on the pathogen.
The most effective antagonist was Trichoderma harzianum, which causes the highest growthinhibition for the three C. camelliae isolates. However, T. asperellum Genkai hardly inhibited the growth of the pathogen isolate EFA 866.2 and was less effective than the other two Trichoderma isolates to antagonize the isolate EFA 909.1. In contrast, Trichoderma asperellum Hisatoni was as effective as T. harzianum to inhibit growth of those two isolates of C. camelliae (EFA 866.2 and EFA 909.1).
Fig.1.Dual culture of Trichoderma asperellum Genkai (T) and C. camelliae EFA 866.5 (C) after 6 days of growth, showing overgrowth of the antagonist.
Our results suggest that T. harzianum Hisatoni and T. asperellum Genkai could be effective antagonists of C. camelliae, given its rapid colony formation and its ability to inhibit growth of C. camelliae in vitro in the short term. The suitability of applying inocula of these Trichoderma isolates as a control method of camellia flower blight must now be tested in greenhouse and field conditions. Some authors have found that fungi showing antagonism under controlled growth conditionsare not effective in the field due to soil characteristics and/or competence with indigenous microbial populations (Garveba et al., 2004).
Table 4. Percent growth inhibition of three isolates of Ciborinia camelliae caused by Trichoderma spp. after 6 days of growth in dual cultures. For each growth parameter, values followed by a different letter are significantly different for P < 0.05.
| Growth inhibition (%) | C. camelliae EFA 866.2 | C. camelliae EFA 866.5 | C. camelliae EFA 909.1 |
| T. asperellum Genkai | 5.0 a | 26.7 ab | 12.5 a |
| T. asperellum Hisatoni | 22.5 b | 22.2 a | 22.5 b |
| T. harzianum Hisatoni | 20.0 b | 33.3 b | 22.5 b |
Benítez T., Rincón A.M., Limón M.C, Codón A.C. 2004. Biocontrol mechanisms of Trichoderma strains. International Microbiology 7: 249-260.
EPPO. 2011. Ciborinia camelliae. http://www.eppo.org/QUARANTINE/listA2. htm. Last access: November 2011.
Garveba P., van Veen J.A., van Elsas J.D. 2004. Microbial diversity in soil: Selection of microbial populations by plant and soil type and implications for disease suppressiveness. Annual Review of Phytopathology 42: 243-270.
Taylor C.H. 2004. Studies of camellia flower blight (Ciborinia camelliae Kohn). PhD Thesis. Massey University, Palmerston North, New Zealand.
van Toor R.F., Jaspers M.V., Stewart A. 2001. Evaluation of acibenzolar-s-methyl for induction of resistance in camellia flowers to Ciborinia camelliae infection. New Zealand Plant Protection 54: 209-212.
van Toor R.F., Jaspers M.V., Stewart A. 2002. Evaluation of Bio-Start™ soil conditioners for control of sclerotia of Ciborinia camelliae. New Zealand Plant Protection 55: 146-149.
van Toor R.F., Jaspers M.V., Stewart A. 2004. Bicarbonate salts and calcium cyanamide suppress apothecial production by Ciborinia camelliae. New Zealand Plant Protection 57: 142-145.
Web design by Tribal Systems